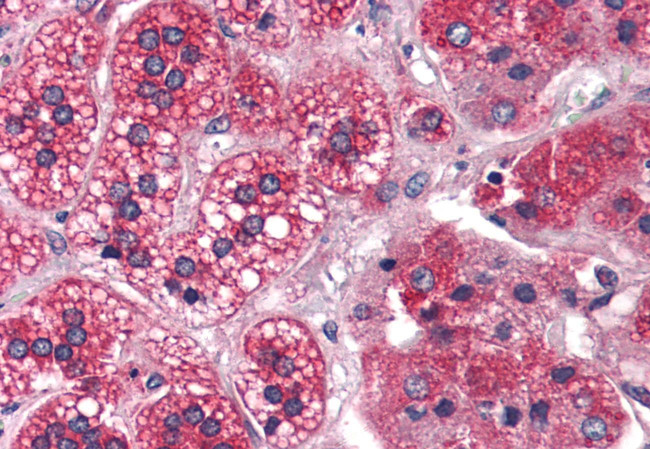
REEP5 Antibody in Immunohistochemistry (Paraffin) (IHC (P))

Search
Invitrogen
REEP5 Polyclonal Antibody
{{$productOrderCtrl.translations['antibody.pdp.commerceCard.promotion.promotions']}}
{{$productOrderCtrl.translations['antibody.pdp.commerceCard.promotion.viewpromo']}}
{{$productOrderCtrl.translations['antibody.pdp.commerceCard.promotion.promocode']}}: {{promo.promoCode}} {{promo.promoTitle}} {{promo.promoDescription}}. {{$productOrderCtrl.translations['antibody.pdp.commerceCard.promotion.learnmore']}}

Please note: We are reviewing Western blot images included in the antibody testing data in our catalog, including those provided by third parties. Unless expressly labeled or annotated as “raw-unedited”, Western blot images included in the antibody testing data in our catalog may have been edited, optimized or otherwise adjusted for presentation.
产品信息
PA5-34152
种属反应
宿主/亚型
分类
类型
抗原
偶联物
形式
浓度
规格
纯化类型
保存液
内含物
保存条件
运输条件
RRID
产品详细信息
Percent identity with other species by BLAST analysis: Human, Orangutan, Gibbon, Monkey, Marmoset, Mouse, Rat (100%) Chicken (93%) Elephant, Platypus (86%).
靶标信息
REEP5 (receptor expression-enhancing protein 5), also known as C5orf18, DP1, TB2 or D5S346, is a 189 amino acid multi-pass membrane protein. Thought to promote the functional cell surface expression of olfactory receptors, REEP5 belongs to the DP1 family and is encoded by a gene that maps to chromosome 5. With 181 million base pairs encoding around 1,000 genes, chromosome 5 is about 6% of human genomic DNA. Chromosome 5 is associated with Cockayne syndrome through the ERCC8 gene and familial adenomatous polyposis through the adenomatous polyposis coli (APC) tumor suppressor gene. Treacher Collins syndrome is also chromosome 5 associated and is caused by insertions or deletions within the TCOF1 gene. Deletion of the parm of chromosome 5 leads to cri du chat syndrome. Deletion of 5q or chromosome 5 altogether is common in therapy-related acute myelogenous leukemias and myelodysplastic syndrome.
仅用于科研。不用于诊断过程。未经明确授权不得转售。
篇参考文献 (0)
生物信息学
蛋白别名: deleted in polyposis 1; GP106; Polyposis locus protein 1; Polyposis locus protein 1 homolog; Protein TB2; protein TB2 homolog; receptor expression enhancing protein 5; Receptor expression-enhancing protein 5
基因别名: AI324241; AU022809; AW495741; C5orf18; DP1; DP1/TB2; R74856; REEP5; TB2; TB2/DP1
UniProt ID: (Rat) B2RZ37
Entrez Gene ID: (Rat) 364838, (Mouse) 13476